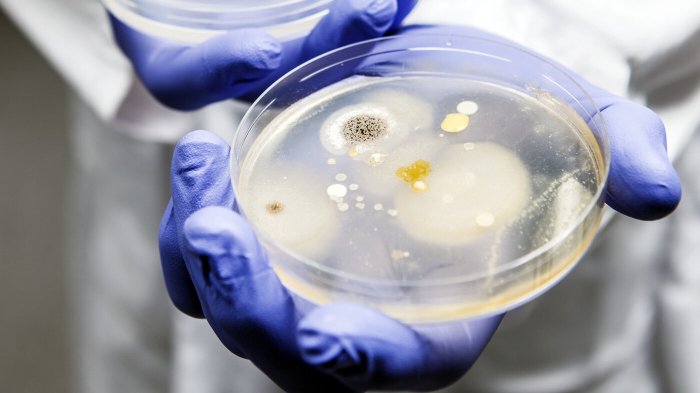

Antibiotika
Myter og fakta om antibiotika og bakterier. Og hva er sykepleierens rolle i antibiotikastyringen? Les deg opp her.

Sykepleiere er viktige bidragsytere i antibiotika-styringen
Sykepleiernes funksjon i antibiotikastyringen er ikke så kjent eller anerkjent som den burde være. Tverrfaglig samarbeid må til for å sikre optimal antibiotikabruk – og kunnskapsrike sykepleiere bør sitte i førersetet.
– Knus mytene om antibiotika
– Det finnes mange myter om antibiotika. De fleste av dem kan med fordel knuses, skriver lederen for Antibiotikasenteret for primærmedisin.

– Vi må slutte fred med bakteriene
– Overforbruk av antibiotika skaper ikke bare resistente bakterier. Det er heller ikke bra for helsen vår, skriver vitenskapsjournalisten.

Antibiotika eller ikke: – Sykepleiere spiller en viktig rolle
Men sykepleiere opplever at de ikke kan nok om resistens og riktig bruk av antibiotika.

Kan sykepleiere på legevakt påvirke om pasienter får antibiotika?
«Hvorfor i all verden har denne pasienten fått time», tok Bent Håkan Lindberg seg i å tenke som lege på legevakt.

Antibiotikaresistens: – Det pågår en usynlig kamp
– Sykepleieren har en sentral rolle i kampen mot antibiotikaresistens. Det gjenspeiles ikke i handlingsplanene, skriver NSF-lederen.

Bakteriene gjør alt de kan for å overleve
De utskiller enzymer, overfører gener og bygger om rustningen sin. For bakteriene står det om livet.

Hva om vidundermedisinen slutter å virke?
Vi har nok store oppgaver foran oss for å sikre gode og likeverdige helsetjenester til innbyggere i hele landet i årene fremover. La oss gjøre alt som står i vår makt for at ikke antibiotikaresistens er enda en av dem.

WHO advarer mot overdreven bruk av antibiotika
Antibiotikaresistens som følge av overdreven bruk av legemiddelet er en av de største truslene mot global helse, matsikkerhet og utvikling, advarer WHO.

Antall sykehusinfeksjoner og bruk av antibiotika på samme nivå i flere år
Antall pasienter som får infeksjon på sykehusene og i sykehjem, har vært lavt i flere år. Likevel er sykehusinfeksjon den hyppigste årsaken til komplikasjoner.

– Bør være like naturlig å spørre om antibiotika som å spørre om smertestillende
Å sette en tentativ sluttdato og skrive den opp på pasienttavlen. Slik ble det fart på revurderingen av antibiotika på UNN.


